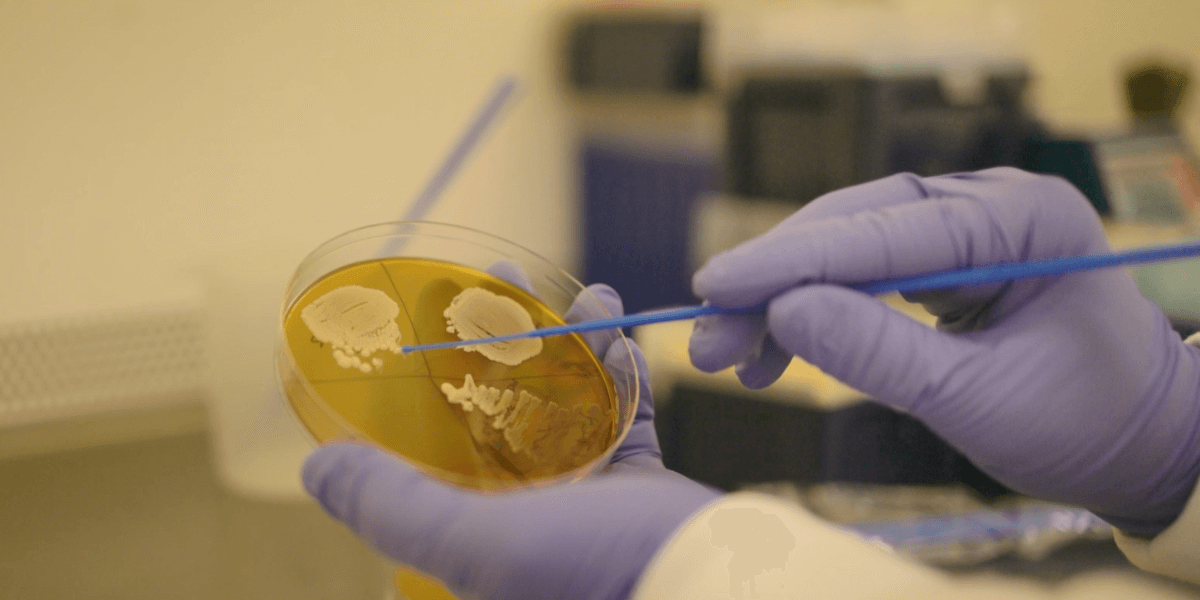
A researcher selects a colony of yeast from an agar plate.

CAMBRIDGE, United Kingdom — The phrase “you are what you eat” might need to be changed to “you age how you eat.” In a recent study, researchers at the Babraham Institute in England suggest that the path to healthy aging might not necessarily lie in cutting calories but rather in optimizing one’s diet. The findings show that the foods we eat, especially in our early years, could determine our health as we age, challenging the previous notion that inevitable poor health comes with aging.
Historically, scientists believed in the benefits of caloric restriction – a regimen where individuals intentionally consume fewer calories than usual without malnutrition. This method has been linked to improved health in a person’s golden years and potentially a longer life. Nonetheless, mouse studies indicate that to reap these benefits, one must maintain caloric restriction throughout their entire life, and the health advantages dissipate if one returns to a regular diet.
However, Dr. Jon Houseley’s team is unveiling a different perspective. Through their experiments on yeast, they’ve discovered a potential alternative to the age-old practice of calorie cutting.
“We show that diet in early life can switch yeast onto a healthier trajectory,” says Dr. Dorottya Horkai, the study’s lead researcher, in a media release. “By giving yeast a different diet without restricting calories we were able to suppress senescence, when cells no longer divide, and loss of fitness in aged cells.”
In a surprising twist, the team did not keep the yeast on their typical glucose-rich diet. Instead, they introduced a galactose diet. The result? Many of the usual molecular changes associated with aging didn’t appear. Even more compelling, these cells didn’t live longer, but they maintained their vitality late in life, reducing the period of poor health typically seen in aging adults.
“Crucially, the dietary change only works when cells are young, and actually diet makes little difference in old yeast,” says Dr. Houseley. “It is hard to translate what youth means between yeast and humans, but all these studies point to the same trend – to live a long and healthy life, a healthy diet from an early age makes a difference.”
Considering yeast shares many cellular attributes with humans, this research could pave the way for new dietary recommendations. While the study offers a promising avenue for improving healthy aging through diet without the challenges of severe calorie restriction, researchers say further investigation is necessary to solidify these findings.
The study is published in the journal PLoS Biology.
You might also be interested in:
